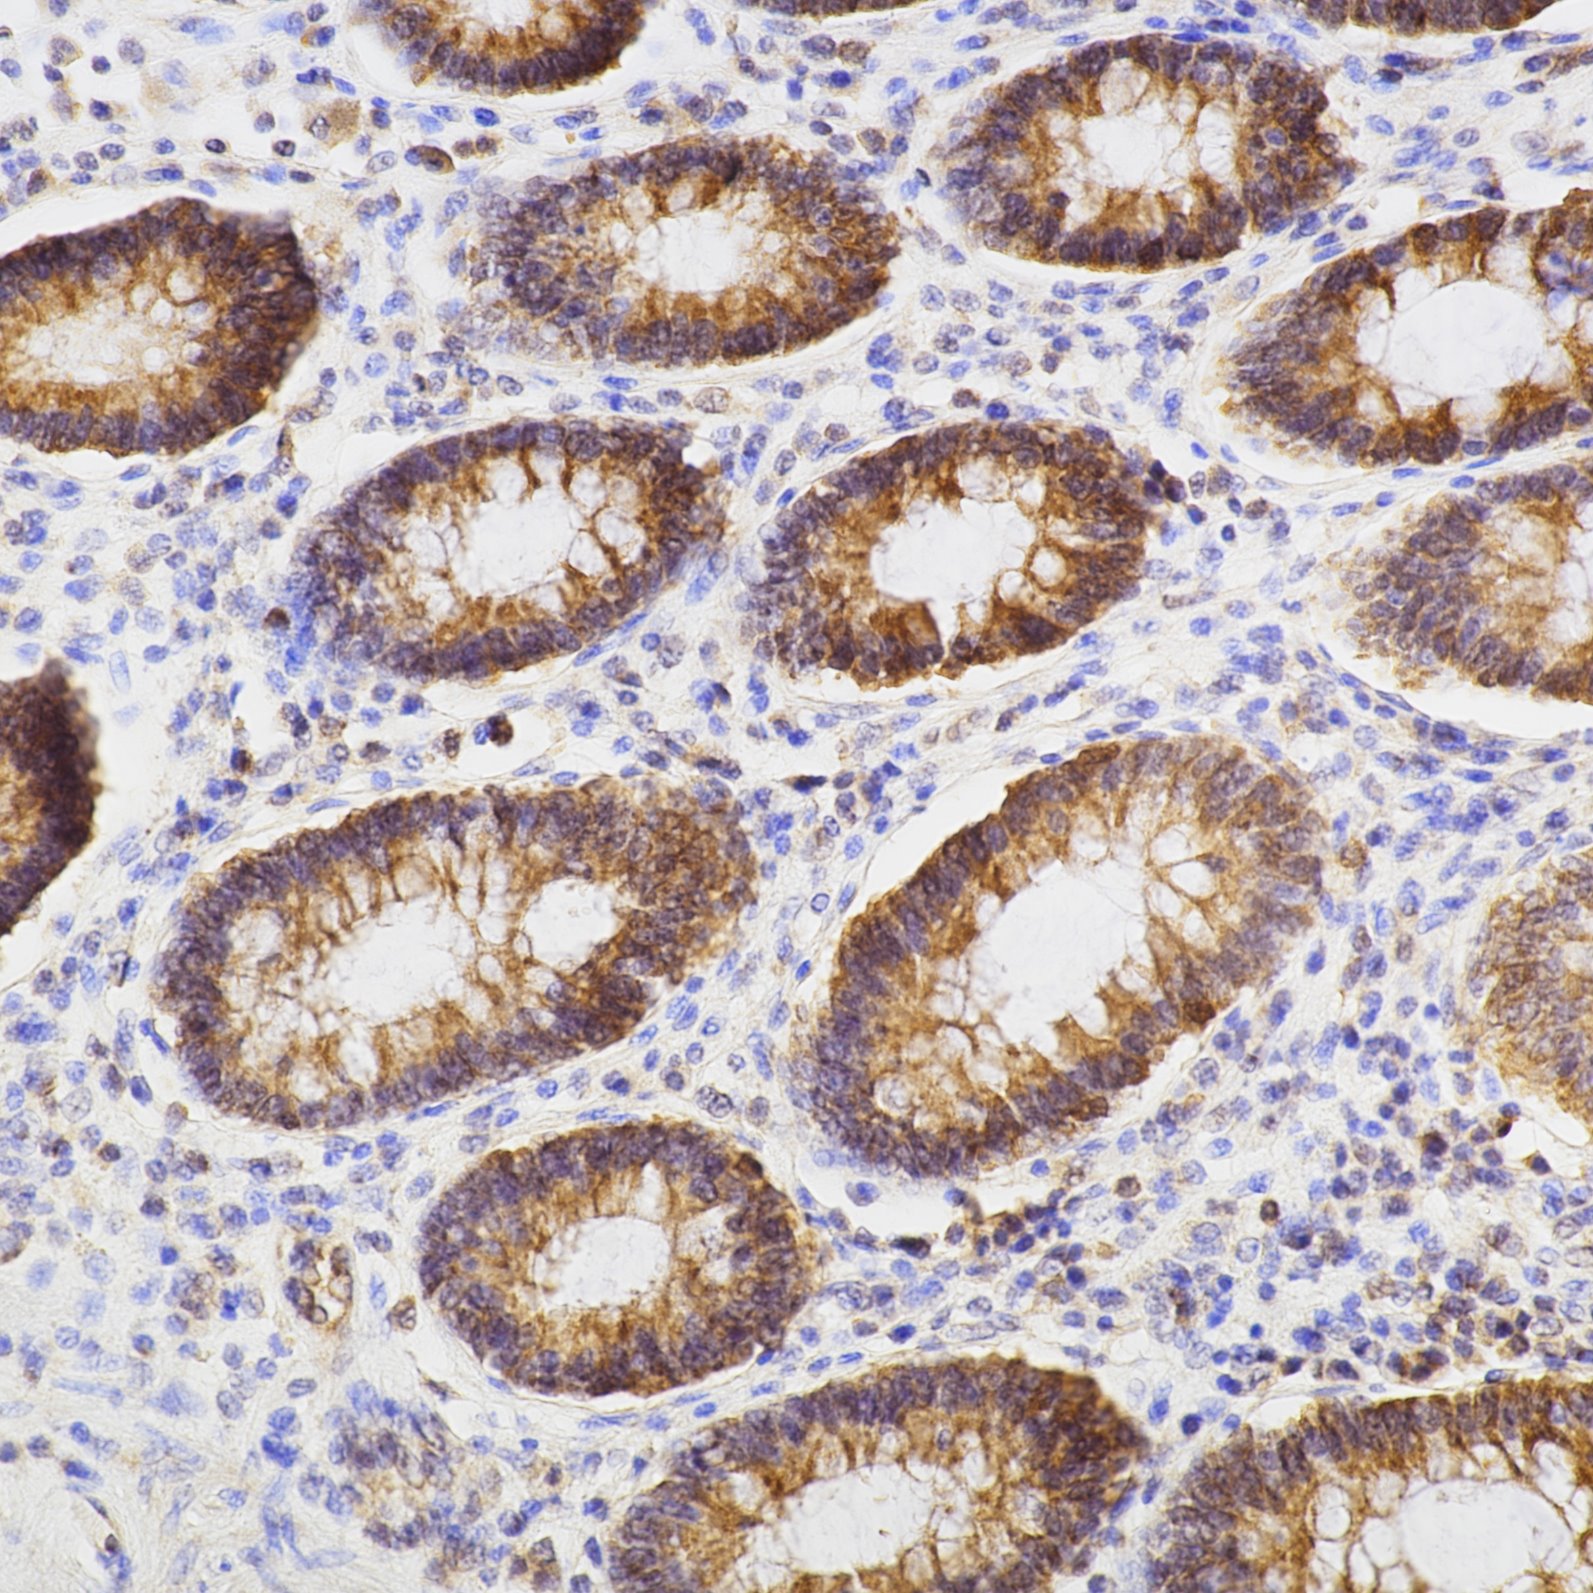
Immunohistochemistry (IHC) staining of human colon tissue using BAX Monoclonal antibody (60267-1-Ig)

Tested Applications
| Positive WB detected in | HeLa cells, EC109 cells, HepG2 cells, human testis tissue, HEK-293 cells, COLO 320 cells, PC-12 cells, ROS1728 cells, Neuro-2a cells |
| Positive IP detected in | THP-1 cells |
| Positive IHC-Autostainer detected in | human colon tissue |
| Positive IHC detected in | human liver cancer tissue, human colon cancer tissue, human kidney tissue, human lung cancer tissue, human rectal cancer tissue, human stomach cancer tissue Note: suggested antigen retrieval with TE buffer pH 9.0; (*) Alternatively, antigen retrieval may be performed with citrate buffer pH 6.0 |
| Positive IF/ICC detected in | MCF-7 cells |
Recommended dilution
| Application | Dilution |
|---|---|
| Western Blot (WB) | WB : 1:5000-1:20000 |
| Immunoprecipitation (IP) | IP : 0.5-4.0 ug for 1.0-3.0 mg of total protein lysate |
| Immunohistochemistry (IHC)-AUTOSTAINER | IHC-AUTOSTAINER : 1:1000-1:4000 |
| Immunohistochemistry (IHC) | IHC : 1:500-1:2000 |
| Immunofluorescence (IF)/ICC | IF/ICC : 1:400-1:1600 |
| It is recommended that this reagent should be titrated in each testing system to obtain optimal results. | |
| Sample-dependent, Check data in validation data gallery. | |
Published Applications
| KD/KO | See 4 publications below |
| WB | See 650 publications below |
| IHC | See 33 publications below |
| IF | See 3 publications below |
| CoIP | See 2 publications below |
Product Information
60267-1-Ig targets BAX in WB, IHC, IHC-Autostainer, IF/ICC, IP, CoIP, ELISA applications and shows reactivity with human, mouse, rat samples.
| Tested Reactivity | human, mouse, rat |
| Cited Reactivity | human, mouse, rat, pig, rabbit, canine, hamster |
| Host / Isotype | Mouse / IgG2b |
| Class | Monoclonal |
| Type | Antibody |
| Immunogen |
CatNo: Ag21068 Product name: Recombinant human BAX protein Source: e coli.-derived, PGEX-4T Tag: GST Domain: 1-192 aa of BC014175 Sequence: MDGSGEQPRGGGPTSSEQIMKTGALLLQGFIQDRAGRMGGEAPELALDPVPQDASTKKLSECLKRIGDELDSNMELQRMIAAVDTDSPREVFFRVAADMFSDGNFNWGRVVALFYFASKLVLKALCTKVPELIRTIMGWTLDFLRERLLGWIQDQGGWDGLLSYFGTPTWQTVTIFVAGVLTASLTIWKKMG Predict reactive species |
| Full Name | BCL2-associated X protein |
| Calculated Molecular Weight | 21 kDa |
| Observed Molecular Weight | 21 kDa |
| GenBank Accession Number | BC014175 |
| Gene Symbol | BAX |
| Gene ID (NCBI) | 581 |
| RRID | AB_2848213 |
| Conjugate | Unconjugated |
| Form | Liquid |
| Purification Method | Protein A purification |
| UNIPROT ID | Q07812 |
| Storage Buffer | PBS with 0.02% sodium azide and 50% glycerol, pH 7.3. |
| Storage Conditions | Store at -20°C. Stable for one year after shipment. Aliquoting is unnecessary for -20oC storage. 20ul sizes contain 0.1% BSA. |
Background Information
BAX, also named as BCL2L4, is a pro-apoptotic member of the Bcl-2 protein family, which plays a pivotal role in controlling cell life and death. Bax largely localizes to the cytoplasm of healthy cells, but accumulates on the outer mitochondrial membrane upon apoptosis induction (PMID: 9108035). BAX can commit a cell to apoptosis by translocation from the cytosol to the mitochondria and permeabilization of the outer mitochondrial membrane, which leads to the release of cytochrome c from mitochondria (PMID: 21763611). The expression of BAX is upregulated by the tumor suppressor protein p53, and BAX has been shown to be involved in p53-mediated apoptosis (PMID: 8183579).
Protocols
| Product Specific Protocols | |
|---|---|
| IF protocol for BAX antibody 60267-1-Ig | Download protocol |
| IHC protocol for BAX antibody 60267-1-Ig | Download protocol |
| IP protocol for BAX antibody 60267-1-Ig | Download protocol |
| WB protocol for BAX antibody 60267-1-Ig | Download protocol |
| Standard Protocols | |
|---|---|
| Click here to view our Standard Protocols |
Publications
| Species | Application | Title |
|---|---|---|
Adv Sci (Weinh) Mitochondrial tRNAGlu 14693A>G Mutation, an "Enhancer" to the Phenotypic Expression of Leber's Hereditary Optic Neuropathy | ||
Acta Pharm Sin B Protocatechuic aldehyde protects cardiomycoytes against ischemic injury via regulation of nuclear pyruvate kinase M2. | ||
Acta Pharm Sin B Melatonin receptor 1a alleviates sleep fragmentation-aggravated testicular injury in T2DM by suppression of TAB1/TAK1 complex through FGFR1 | ||
Cell Death Differ ZNF451 collaborates with RNF8 to regulate RNF168 localization and amplify ubiquitination signaling to promote DNA damage repair and regulate radiosensitivity | ||
J Adv Res Evolocumab prevents atrial fibrillation in rheumatoid arthritis rats through restraint of PCSK9 induced atrial remodeling | ||
Cell Rep Med High-dose ascorbic acid selectively induces pyroptosis in LKB1-deficient lung cancer and sensitizes immunotherapy |